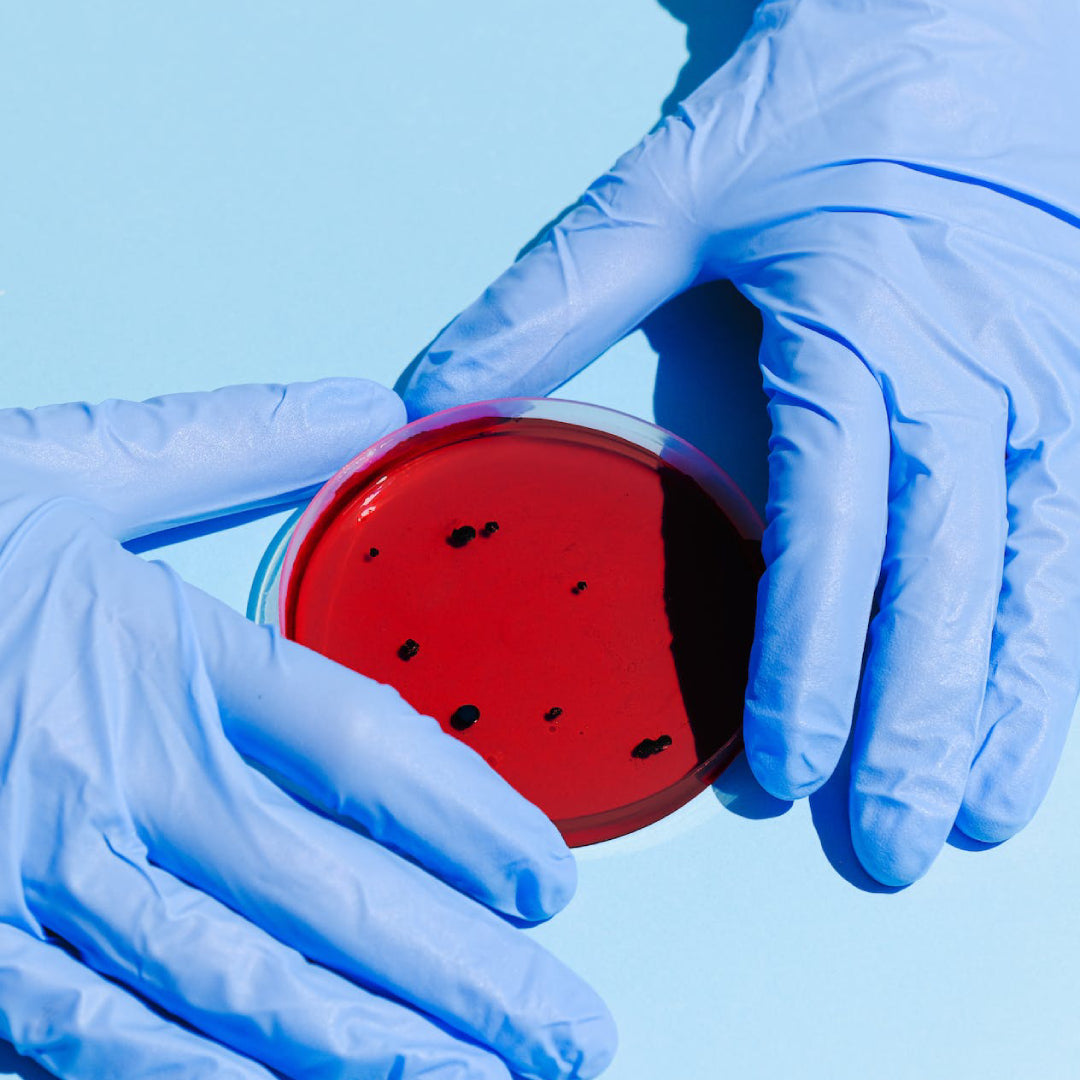

Getting your sample sent to CTLA

Who We Are
At CTLA, we are more than a testing laboratory – we are your partners in ensuring that your products meet the highest standards set by regulatory authorities. With a focus on integrity, precision, and ethical practices, we stand as your trusted ally in the intricate world of product safety and compliance.
Our Mission
Our mission is clear: to empower businesses to thrive by providing unparalleled testing services that not only meet but exceed industry standards. We believe in fostering a safer, healthier world through the products we test, ensuring that every item that reaches the market is synonymous with quality and trust.

What sets us apart
- Comprehensive Expertise: With a team of seasoned professionals, CTLA brings a wealth of knowledge and expertise in dietary supplement, food, and cosmetic testing.
- Cutting-Edge Technology: We embrace innovation, employing the latest technologies and advanced testing methods to deliver accurate and reliable results.
- Ethical Testing Practices: CTLA is proud to be a cruelty-free laboratory, championing alternatives to animal testing and promoting responsible practices within the industry.
Our Promise
CTLA pledges unwavering commitment to transparency, accuracy, and exceptional customer service. We understand that behind every product, there is a story of dedication, innovation, and passion. Let us be the guardians of your story, ensuring it unfolds with the utmost safety and credibility.





